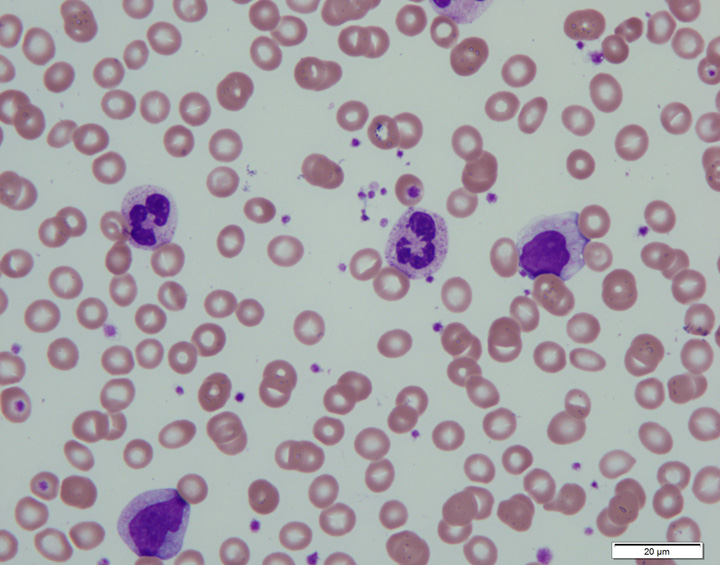
顕微鏡で見た血液像

部門紹介
中央検査部では、血液・尿・便などを検査する検体検査部門と、心電図・脳波などの生理検査部門に加え、採血などの各種検体採取に国家資格を持つ臨床検査技師が業務を行っています。
正確な検査結果を報告するため、ISO15189認定をはじめ、日本臨床衛生検査技師会、岐阜県臨床検査技師会、日本医師会が主催する精度管理調査に参加し精度保証された信頼性の高い検査データを提供しています。
また、ISO15189の教育手順に従いスタッフ教育を進めています。日々進化する医療の知識を共有するため定期的な勉強会を開催するとともに学会や研修会にも積極的に参加しています。
施設認定等
- ISO 15189 認証
当中央検査部は、2020年3月24日 ISO 15189 の認定を取得し、2023年10月4日に更新をいたしました。
これからも、日々検査業務の質改善に取り組んでいきます。

- 日本臨床衛生検査技師会 品質保証施設認証
- 検体管理加算Ⅳ
臨床検査室品質方針
- 良質な臨床検査サービスを提供することで、健康で豊かな社会作りに貢献する。
- 臨床検査室の規定とISO15189の要求事項を遵守し、依頼者の要求に対して適格で高品質な臨床検査サービスを提供し続ける。
- 臨床検査サービスの利用者の満足する品質を維持するため、品質目標を設定し、常にサービスの内容を見直す。
- 臨床検査室に所属するスタッフ全員が臨床検査室の規定する品質マネジメントシステムを理解する。
- 臨床検査室は、マネジメントレビューにおいて品質マネジメントシステムの運用・維持・改善に関してレビューし評価する。
スタッフ紹介
担当チーフと各担当職員数(2025年11月1日現在)
血液・一般検査担当チーフ 後藤 雪乃
生化・免疫検査担当チーフ 仲本 知代
検体検査:臨床検査技師 22名、非常勤事務 3名
採血室:非常勤准看護師 7名
微生物検査担当チーフ 大西 紀之
微生物検査:臨床検査技師 9名
生理検査担当チーフ 飯田 佳子
生理検査:臨床検査技師 10名
職員認定資格(2025年11月1日現在)
- 二級臨床検査士(循環生理、微生物学、免疫・血清学、血液学) 10名
- 緊急臨床検査士 16名
- 認定血液検査技師 4名
- 認定輸血検査技師 1名
- 認定心電検査技師 1名
- 認定一般検査技師 1名
- 認定臨床微生物検査技師 3名
- POCT測定認定士 1名
- 感染制御認定臨床微生物検査技師(ICMT) 3名
- 心臓リハビリテーション指導士 2名
- JHRS認定心電図専門士 2名
- 遺伝子分析化学認定士(初級) 1名
- 日本輸血・細胞治療学会 I&A(視察と認証)視察員 1名
- 日本糖尿病療養指導士 1名
- 超音波検査士(循環器、消化器、血管、体表) 11名
- 精度管理責任者 1名
- 臨床検査技師臨地実習指導者 3名
- 岐阜県肝炎医療コーディネーター 6名
- 特定化学物質及び四アルキル鉛等作業主任者 3名
- 有機溶剤作業主任者 4名
- 医療安全管理者 3名
- タスク・シフト/シェアに関する厚生労働大臣指定講習会 38名
業務内容
検体検査担当
迅速な結果報告を心掛けており、精度の高い結果報告のため、検査機器の点検・整備、内部精度管理にて日々の精度の担保を行い、外部精度管理では良好な結果を得ています。

検体検査室 全景(2025年1月から、検体搬送システムが稼働しています。)
採血室(外来採血)
外来患者さんの採血を行っています。中央採血室は7ブース、第2採血室は2ブースにて、1日平均400名の採血を行い、種々の血液検査・生化学検査へ提供しています。なお、第2採血室は、消化器内科、糖尿病・内分泌内科の患者さんを対象とし、11時まで行っております。採血待ち時間を短くするため、一層の努力を行っていきます。


中央採血室

中央採血室

第2採血室

第2採血室
一般検査
尿・便・体腔液・髄液等について、化学的、顕微鏡的な検査をしています。
尿検査では、尿中の成分や細胞を調べ、腎臓や膀胱の疾患や状態を調べます。便検査では、消化管の出血や寄生虫等を検査しています。

左から全自動尿中有形成分分析装置(UF5000)、全自動尿分析装置(AUTION MAX)、 全自動尿分取装置 (UA-ROBO)
血液検査
4台の自動測定機器により、白血球、赤血球、血小板などの細胞の数、血液像を検査しています。
この検査では、貧血の有無や種類の判定、治療の効果判定、炎症の推定、血液疾患の診断に用いられます。

多項目自動血球算定装置(XR9000)

塗抹標本作成装置(SP50)
顕微鏡で見た血液像
凝固検査
凝固検査は、血液の固まりやすさや出血の止まりにくさを検査します。
項目には、PT、APTT、フィブリノーゲン、FDP、Dダイマー、ATⅢなどがあります。

全自動血液凝固分析装置(CN6000)
生化学検査
生化学検査では血液中や尿中に含まれる成分を分析しています。肝機能、腎機能、脂質代謝、糖代謝に関する検査を実施しています。
検査の流れとしては、患者さんから採血した血液を遠心分離します。次に分離した検体を分析機で測定します。臨床検査技師が結果を確認後、医師へ報告しています。

全自動分注装置(IDS-CLAS3600)

全自動生化学分析装置(LABOSPECT008α)
免疫検査
免疫検査では肝炎ウイルス、HIV、梅毒等の感染症の検査や腫瘍マーカー、内分泌検査、血液中薬物濃度の検査を実施しています。

全自動免疫測定装置(ルミパルス L2400)

全自動免疫測定装置(Alinity i)
輸血検査(輸血部)
安全な輸血療法のために、血液型検査、不規則抗体検査、交差適合試験、直接・間接クームス試験等を実施しています。
輸血の検査の流れとしては、まず血液型の検査をします。A・B・O・ABとRhD(+)・(-)について検査し、同じ血液型の血液を準備します。次に、実際に輸血する血液と患者さんの血液を混ぜ合わせて、何も反応が起こらないかを検査します(交差適合試験)。 検査の結果、輸血しても大丈夫と判定された血液が手術や治療のために使用されます。
また、必要に応じて不規則抗体検査や直接・間接クームス試験等を実施しています。

全自動輸血検査機器(ORTHO VISION)

輸血検査用試薬とドライバス(恒温槽)
2024年度 検体検査実績
- 採血:98,747件
- 一般検査:1,016,529件
- 血液検査:1,185,611件
- 免疫検査:234,332件
- 生化学検査:2,972,193件
- 輸血検査:23,302件
- 新型コロナ抗原定量検査:7,048件
微生物検査担当
患者さんから提出された様々な検査材料から感染症の原因となる病原菌を検出し、どの治療薬(抗菌薬)が効くのかを検査しています。
ICT(感染対策チーム)の活動(週1回のICTラウンドやICTミーティング)に参加し、院内の感染対策に貢献しています。また、毎朝行われるマイクロミーティング(ICTのメンバーが微生物検査室に集まり、感染症患者の情報を共有します)では、血液培養の陽性結果や新規MRSA患者等の情報を提供しています。
また、微生物検査担当者が休日も出勤し微生物検査業務を行うことにより、血液培養陽性報告や抗酸菌報告を迅速に行っています。
検査の流れ
微生物検査室に提出された検体は、材料ごとに適切な培地に塗布し、培養していきます。感染防止の為、安全キャビネットの中で検体を扱います。
検体を処理する際には、スライドガラスに検体を塗りグラム染色を行い、顕微鏡にてどのような菌がいるのか、白血球がいるのかを確認します。
1日培養し、検体ごとに起炎菌と思われる菌をピックアップします。

安全キャビネット

中央が白血球、小さな青いものが細菌です

血液培養装置(FX)

微生物分類同定分析装置
(MALDI Biotyper Smart)
提出された検体ごとに、どのような菌が検出されて、どのような抗菌薬が使用できるか報告をします。
また、抗酸菌検査(結核菌)の検査も実施しています。抗酸菌と思われる菌を見つけた時には、結核菌かどうか遺伝子検査も実施しています。
院内の感染防止の為に、感染防止委員会に感染症の発生状況を報告しています。また、耐性菌(薬が効きにくい菌)が検出されたときには、ICTに報告しています。
平成27年にはPOT法を導入し、MRSA(メチシリン耐性黄色ブドウ球菌)の遺伝子型を調べ院内感染対策に役立っています。

微生物同定感受性分析装置
(マイクロスキャン WalkAway 96Plus)
2024年度 微生物検査実績
- 一般細菌:15,462件
- 血液培養:9,244件
- 抗酸菌:2,662件
- SARS-CoV-2関連遺伝子検査:2,132件
生理検査担当
生理的な生体の情報を記録、測定する検査です。心電図検査・ホルター心電図検査、肺機能検査、脳波検査、血圧脈波検査・皮膚灌流圧測定検査、睡眠時無呼吸検査、心肺運動負荷試験、聴覚検査などの検査があります。
心電図検査は、時間外も当直者にて24時間対応しています。負荷心電図、心肺運動負荷試験(CPX)の検査時は、万一に備え医者の立会いのもと行っています。生理検査の種類は多岐にわたりますが、それぞれに専門的知識、技能を有したスタッフが対応しておりますので、検査に対する不安や疑問などありましたら遠慮なくお尋ねください。
同性の技師を希望される方は、受付にお伝えください。ただし、その場合には待ち時間があることや順番が前後することがありますのでご承知ください。
心電図検査・ホルター心電図検査
心臓の電気的活動を調べる検査です。不整脈や心筋梗塞の診断に役立ちます。
心電図の検査では、両手首・両足首・胸に電極を取り付けますので、手首・足首・胸が出しやすい服装でお願いします。

心電図検査装置(FCP-9800)
負荷心電図の場合には、階段を上り下りしてもらう検査を行います。
ホルター心電図は、翌日、機械を外しに来ていただく必要があります。行動記録カードの記入もお願いします。

マスター台
肺機能検査
息を吸ったり吐いたりすることで肺の大きさや働きを見る検査です。
呼気NOは食事の影響を受けますので、当日は食事を控えていただくか、食事から2時間程度空けてから検査を行います。

肺機能検査装置(FUDAC7C)
脳波検査
脳の電気的活動を調べる検査です。てんかんや脳血管障害の診断に役立ちます。
検査は1時間程度かかりますので、事前にトイレを済ませておいてください。
3歳位までのお子様は眠った状態で検査を行うこともあります。その場合は検査当日は予約時間より1時間程度早く来院してください。


脳波検査装置(EEG-1284)
血圧脈波検査・皮膚灌流圧測定検査
手足の血圧を同時測定し、血管のつまりや動脈硬化の程度を調べます。皮膚血流の灌流状態を調べ、皮膚レベルの血流評価をします。
血圧計を装着しますので、上着を脱いでもらうことがあります。

皮膚灌流圧測定検査装置(PAD4000)
睡眠時無呼吸検査
睡眠中に何度も呼吸が止まる睡眠時無呼吸症候群の診断に役立ちます。
平日の夕方に入院していただき、19時頃から機械を取り付け翌朝まで検査を行います。
簡易の機器もあります。この場合には、ご自宅で機械とセンサーを装着して頂き、翌日の朝、取り外して検査室に届けていただきます。

睡眠時無呼吸検査装置装着状態

簡易アプノモニター
心肺運動負荷試験(CPX)
心電図、血圧、呼気中の酸素、二酸化炭素の濃度を計測しながら運動していただきます。 心臓だけでなく、肺や運動に使われる筋肉の状態等を総合的に評価する検査です。

心肺運動負荷試験実施状態
聴覚検査
耳鼻科外来の聴覚検査室にて行います。中央検査部技師が出向して検査を担当しています。
2024年度 生理検査実績
- 心電図:31,457件
- ホルター:1,064件
- 肺機能:2,777件
- 脳波:726件
- 血圧脈波:1,431件
- CPX:354件
ISO15189公開情報
教育研修・施設見学
中央検査部では、臨時見学を受け付けています。
当検査部の業務に興味を持たれた方は、下記の方法にて申し込みをお願い致します。
なお、見学日程は申し込み後、別途相談させていただきます。
研修、見学を希望される方
「岐阜県総合医療センターホームページ」→「採用情報」→「病院見学申し込みフォーム」からお問い合わせください。
たかはし よしと
高橋 義人
| 役職 |
|
|---|

ながや まき
長屋 麻紀
| 役職 |
|
|---|
おおにし のりゆき
大西 紀之
| 役職 |
|
|---|
ふくおか れい
福岡 玲
| 役職 |
|
|---|
中央検査部では、2019年度にISO15189を取得後、年間計画に沿って日々の業務を行っています。
2025年度 QMS計画表
中央検査部
中央検査部では、血液・尿・便などを検査する検体検査部門と、心電図・脳波などの生理検査部門に加え、採血などの各種検体採取に国家資格を持つ臨床検査技師が業務を行っています。
正確な検査結果を報告するため、ISO15189認定をはじめ、日本臨床衛生検査技師会、岐阜県臨床検査技師会、日本医師会が主催する精度管理調査に参加し精度保証された信頼性の高い検査データを提供しています。
また、ISO15189の教育手順に従いスタッフ教育を進めています。日々進化する医療の知識を共有するため定期的な勉強会を開催するとともに学会や研修会にも積極的に参加しています。
職員認定資格(2025年11月1日現在)
- 二級臨床検査士(循環生理、微生物学、免疫・血清学、血液学) 10名
- 緊急臨床検査士 16名
- 認定血液検査技師 4名
- 認定輸血検査技師 1名
- 認定心電検査技師 1名
- 認定一般検査技師 1名
- 認定臨床微生物検査技師 3名
- POCT測定認定士 1名
- 感染制御認定臨床微生物検査技師(ICMT) 3名
- 心臓リハビリテーション指導士 2名
- JHRS認定心電図専門士 2名
- 遺伝子分析化学認定士(初級) 1名
- 日本輸血・細胞治療学会 I&A(視察と認証)視察員 1名
- 日本糖尿病療養指導士 1名
- 超音波検査士(循環器、消化器、血管、体表) 11名
- 精度管理責任者 1名
- 臨床検査技師臨地実習指導者 3名
- 岐阜県肝炎医療コーディネーター 6名
- 特定化学物質及び四アルキル鉛等作業主任者 3名
- 有機溶剤作業主任者 4名
- 医療安全管理者 3名
- タスク・シフト/シェアに関する厚生労働大臣指定講習会 38名
新人研修
4月に、中央検査部 オリエンテーション計画に沿って、研修が始まります。
中央検査部オリエンテーション計画(例)

新規採用者研修予定表(例)
新規採用者は、全部署を1か月ごとローテーションした後に担当配属されます。

初期研修計画
検体検査担当
初期研修方針:検体検査受付業務を取得し、担当分野の結果報告が単独でできる。また、精度管理や機器のメンテナンスができる。
| 勤務年数 | 概要 | 目指す資格 |
|---|---|---|
| 1年目 | 検体受付業務全般の習得 担当分野の結果報告が実施できる 検査機器の日常メンテナンスが実施できる |
|
| 2~3年目 | 血液像検鏡が実施できる 検査機器の特殊メンテナンス、トラブル対応が実施できる 複数分野の技術を習得し実施できる 学生実習および当直研修の指導が実施できる 学会発表 |
緊急臨床検査士 |
| 3年目以上 | 骨髄像検鏡が実施できる 精度管理の設定・評価が単独でできる 新規配属研修の指導ができる 学会発表 |
認定血液検査技師 認定一般検査技師 日本糖尿病療養指導士 認定輸血検査技師 |
微生物検査担当
初期研修方針:微生物検査業務全体の流れが把握でき、正確・迅速に結果報告できる。
| 勤務年数 | 概要 | 目指す資格 |
|---|---|---|
| 1年目 | 以下の微生物検査業務をできるようにする 検体受付、検体処理、グラム染色・抗酸菌染色・鏡検 マイコプラズマ・結核菌群 Lamp 法、 血液培養陽性検体処理・報告 釣菌・純培養 同定・感受性試験・耐性菌検査 結果報告 |
|
| 2~3年目 | 感染対策(ICT活動)への参加 新人指導 資格獲得 学会発表 |
二級臨床検査士(微生物学) |
| 3年目以上 | 感染対策(ICT活動)への参加 新規配属研修の指導 資格獲得 学会発表 |
認定微生物検査技師 感染制御認定微生物検査技師 (ICMT) |
生理検査担当
初期研修方針:検査機器に慣れ、迅速に正確な報告ができるようにするとともに、患者に優しく丁寧な態度で接する。
| 勤務年数 | 概要 | 目指す資格 |
|---|---|---|
| 1年目 | 接遇 心電図(12誘導・15誘導・自律神経検査等) 血圧脈波、ホルター心電図取付、負荷心電図 肺機能検査・AABR・脳波 |
|
| 2~3年目 | CPX、ABR、MCV、聴力検査、SPP、 ホルター心電図解析 感染対策の指導 |
緊急臨床検査士 |
| 3年目以上 | 新規配属研修の指導 認定資格 学会発表 |
認定心電図検査技師 心臓リハビリテーション指導士 二級臨床検査士(循環生理・神経生理・呼吸生理) 日本糖尿病療養指導士 |
新規採用者は、2~3年ごとのローテーション後、検査部内の業務が可能となります。その後、プロフェッショナルな技師を目指して、専門的な知識や経験を積んでもらいたいと思います。
連絡会
毎月1回、中央検査部の全員を対象にした中央検査部連絡会・勉強会を行っています。
院内の各種委員会からの報告や各担当からの伝達事項等を全体に周知します。また、検査部内での検討事項についての話し合い等を行います。これにより共有すべき情報を全員が把握できるように努めています。医療安全からの報告も行われ、注意すべきインシデントや問題点の報告などが行われます。
勉強会は、検査に関する内容について各担当が持ち回りで行います。これとは別に当直ミニレクチャーという当直に関する内容に特化した勉強会も開催し、テストにて検査技術レベル評価と維持に努めています。
ISO連絡会も同時に開催され、ISO15189に特化した連絡事項や勉強会が行われます。










